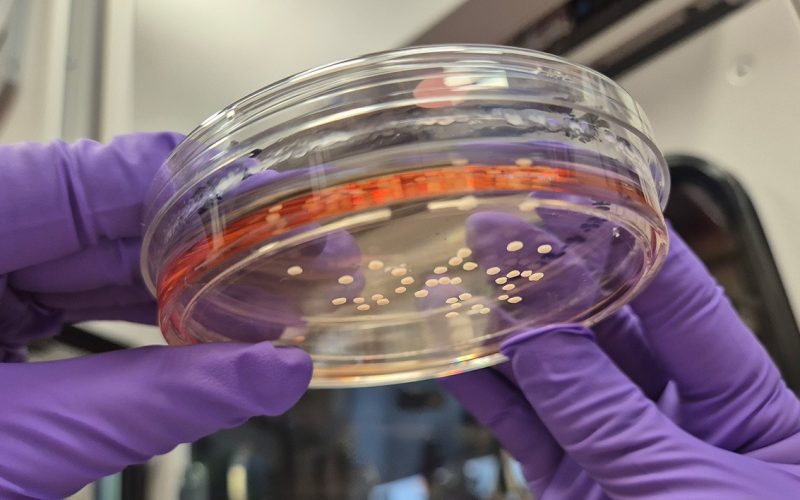
ERC Starting Grant Noelia Anton Balanos

Noelia Antón Bolaños, neuroscientist at UMC Utrecht, has been awarded a prestigious ERC Starting Grant of 1.5 million for her project NeuroSync. With this funding, she will spend the next five years investigating why and how certain regions of the brain develop with a specific timing and order, to build the final circuitry that defines the human brain.
In the growing human brain, not everything develops at the same time: different brain regions mature at their own pace. At the same time, they need to work together to form a fully functional brain. One of the most important components is the thalamus, which can be seen as our ‘sensory hub’. It gathers all sensory information from the outside world, filters it, and then passes it on to the cerebral cortex, which serves as our computing system.
“During development the thalamus communicates with the subplate, a temporary developmental area in the cerebral cortex that acts like a construction site. The subplate helps set up the very early connections between the thalamus and the cortex, ensuring that the foundation of the cerebral cortex is built correctly,” explains Noelia
In humans, the synchronization between the thalamus, subplate, and cortex occurs earlier than in other animals. These connections begin forming early in pregnancy, while in animals they develop much later. This early coordination allows the thalamus to shape the cerebral cortex in a unique way. Noelia: “Studying this fascinating process helps us understand how cell types diversify, regions become interconnected, and how these interactions contribute to the specialized functions that make human brains so remarkable.”
Dr. Noelia Antón Bolaños
Noelia and her team will use innovative models based on human stem cells to study how early coordination works. She developed these models, known as Forebrain Chimeroids, during her postdoc at Harvard University. They replicate the development of the thalamus, subplate, and cortex in a petri dish, allowing researchers to observe how cells communicate and how the brain forms its unique structures, step by step
“It is an incredible honor to receive this ERC Starting Grant,” says Noelia. “It gives us the opportunity to gain fundamental understanding of how human brains develop and what makes this process so special. I am very excited to start this project with my team.”
Noelia’s team will also investigate what happens when these events are disrupted. These very early fetal processes are highly susceptible during pregnancy. Disturbances in the cooperation between brain regions can contribute to developmental disorders such as autism, schizophrenia or early-life (infant) epilepsy. By gaining a better understanding of what normal brain development looks like, Noelia and her team hope to gain insights that could eventually help develop new treatments.
With NeuroSync, we aim not only to discover how the brain works, but also to understand why some people are more vulnerable to brain disorders and what could have gone wrong during pregnancy,” explains Noelia. “The idea that our research could contribute to a better future for patients makes this work especially meaningful.”